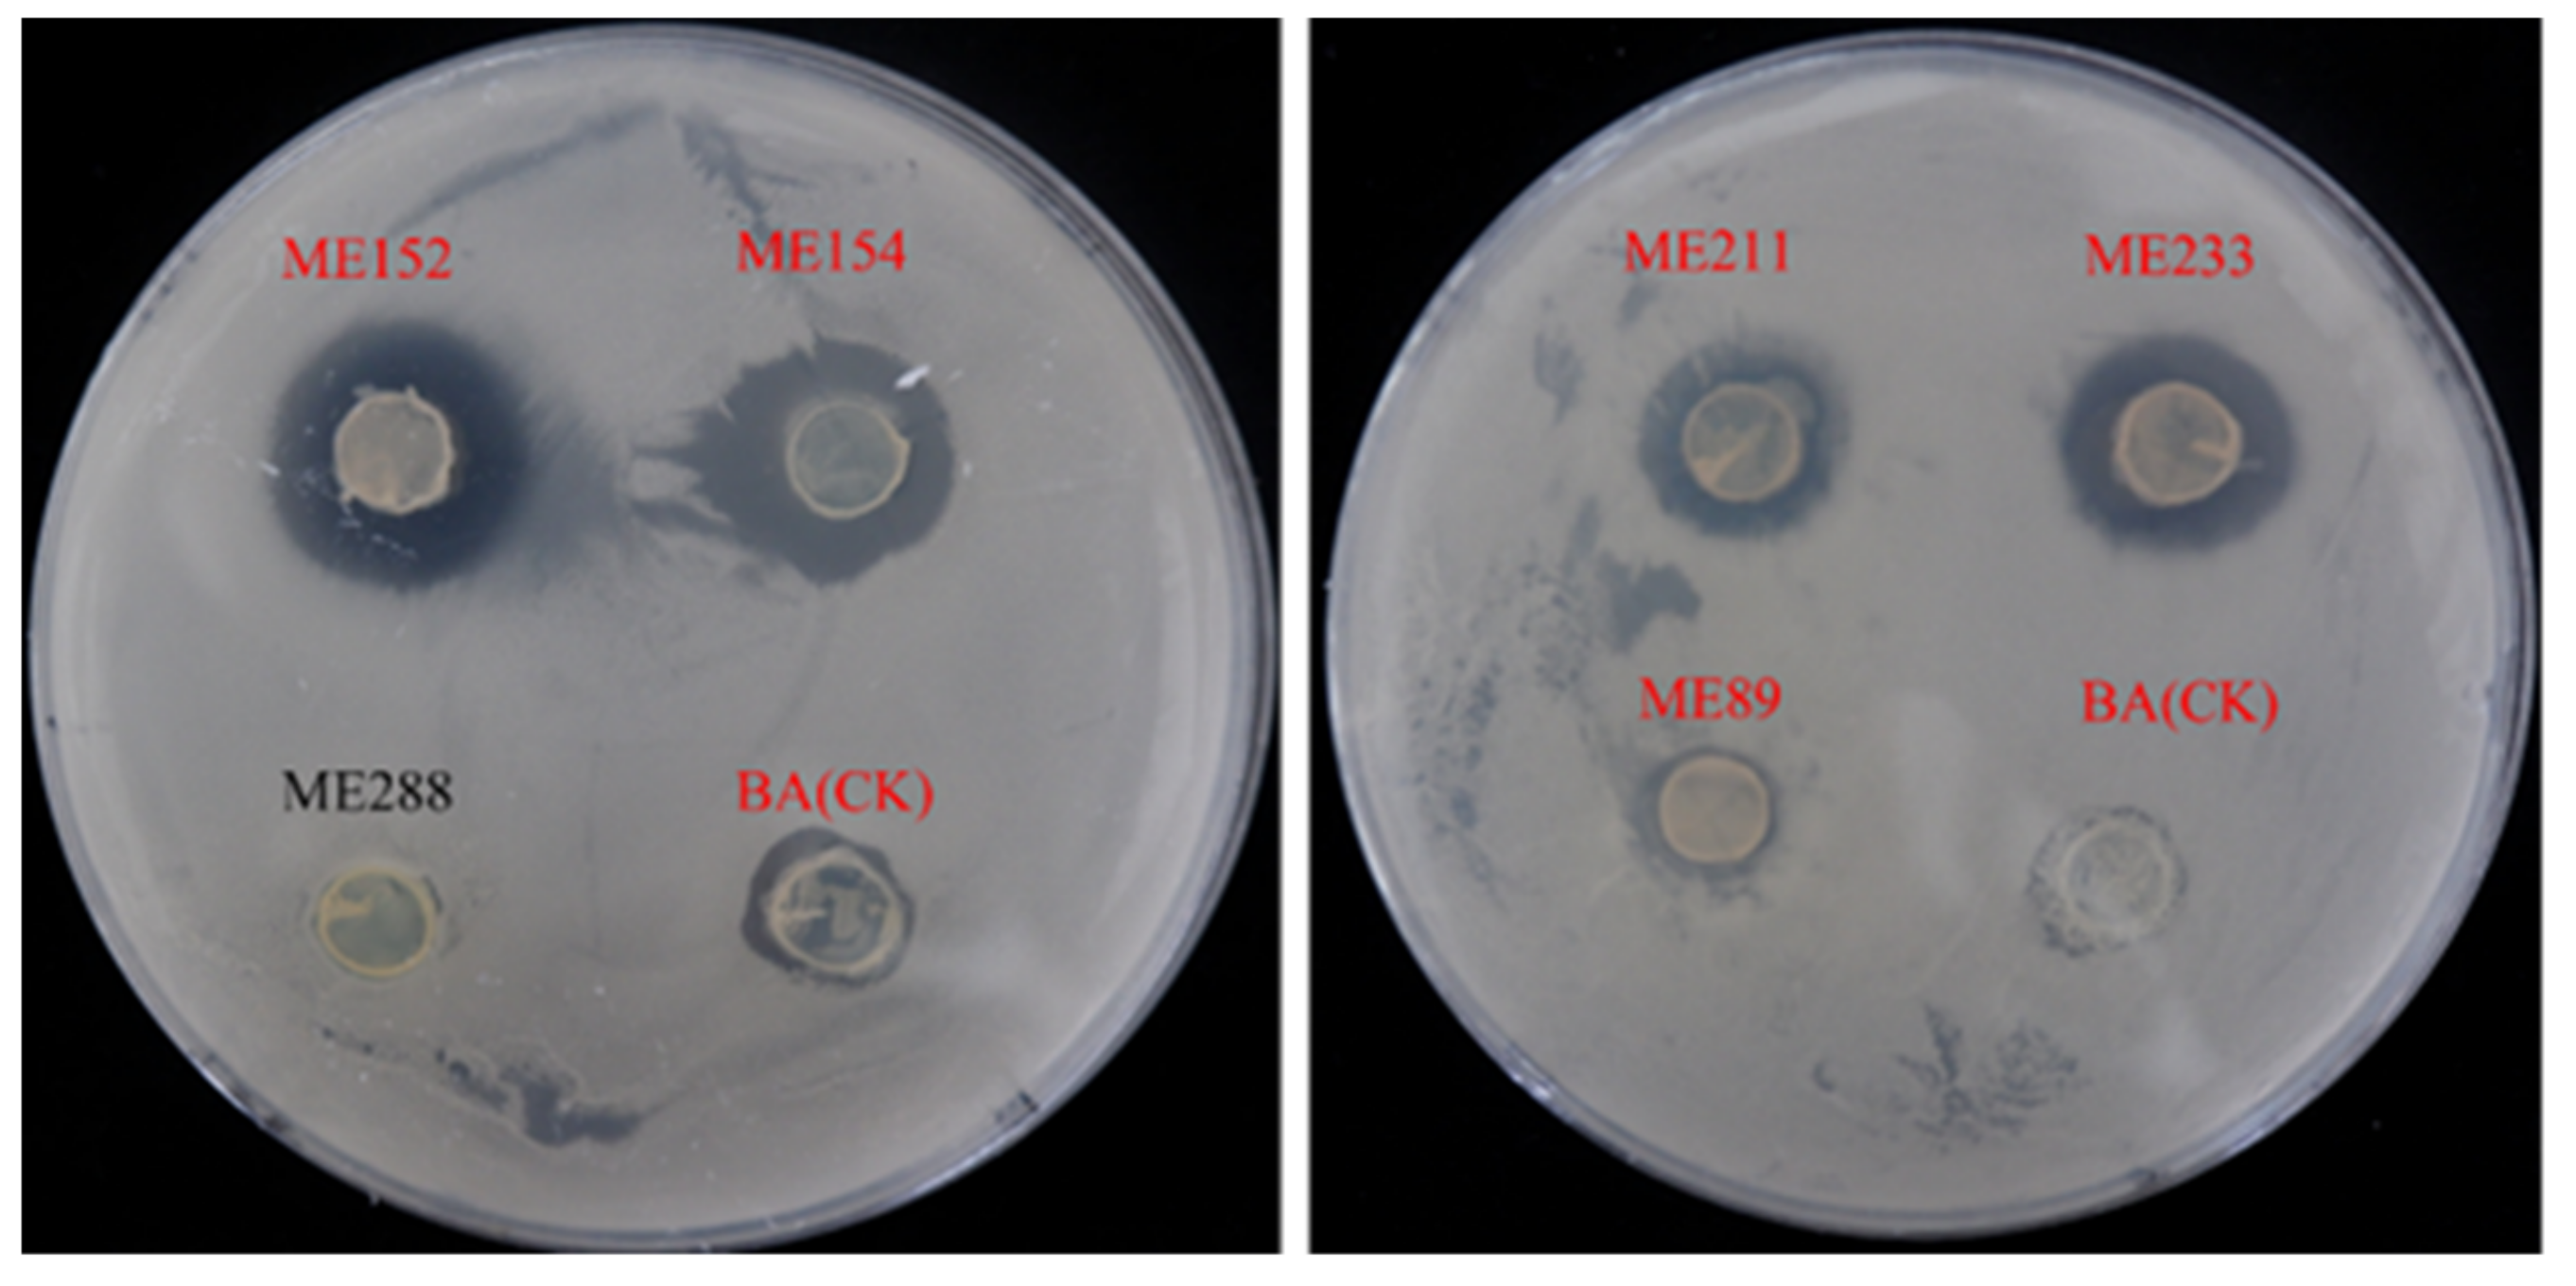
Biology 12 01231 g001
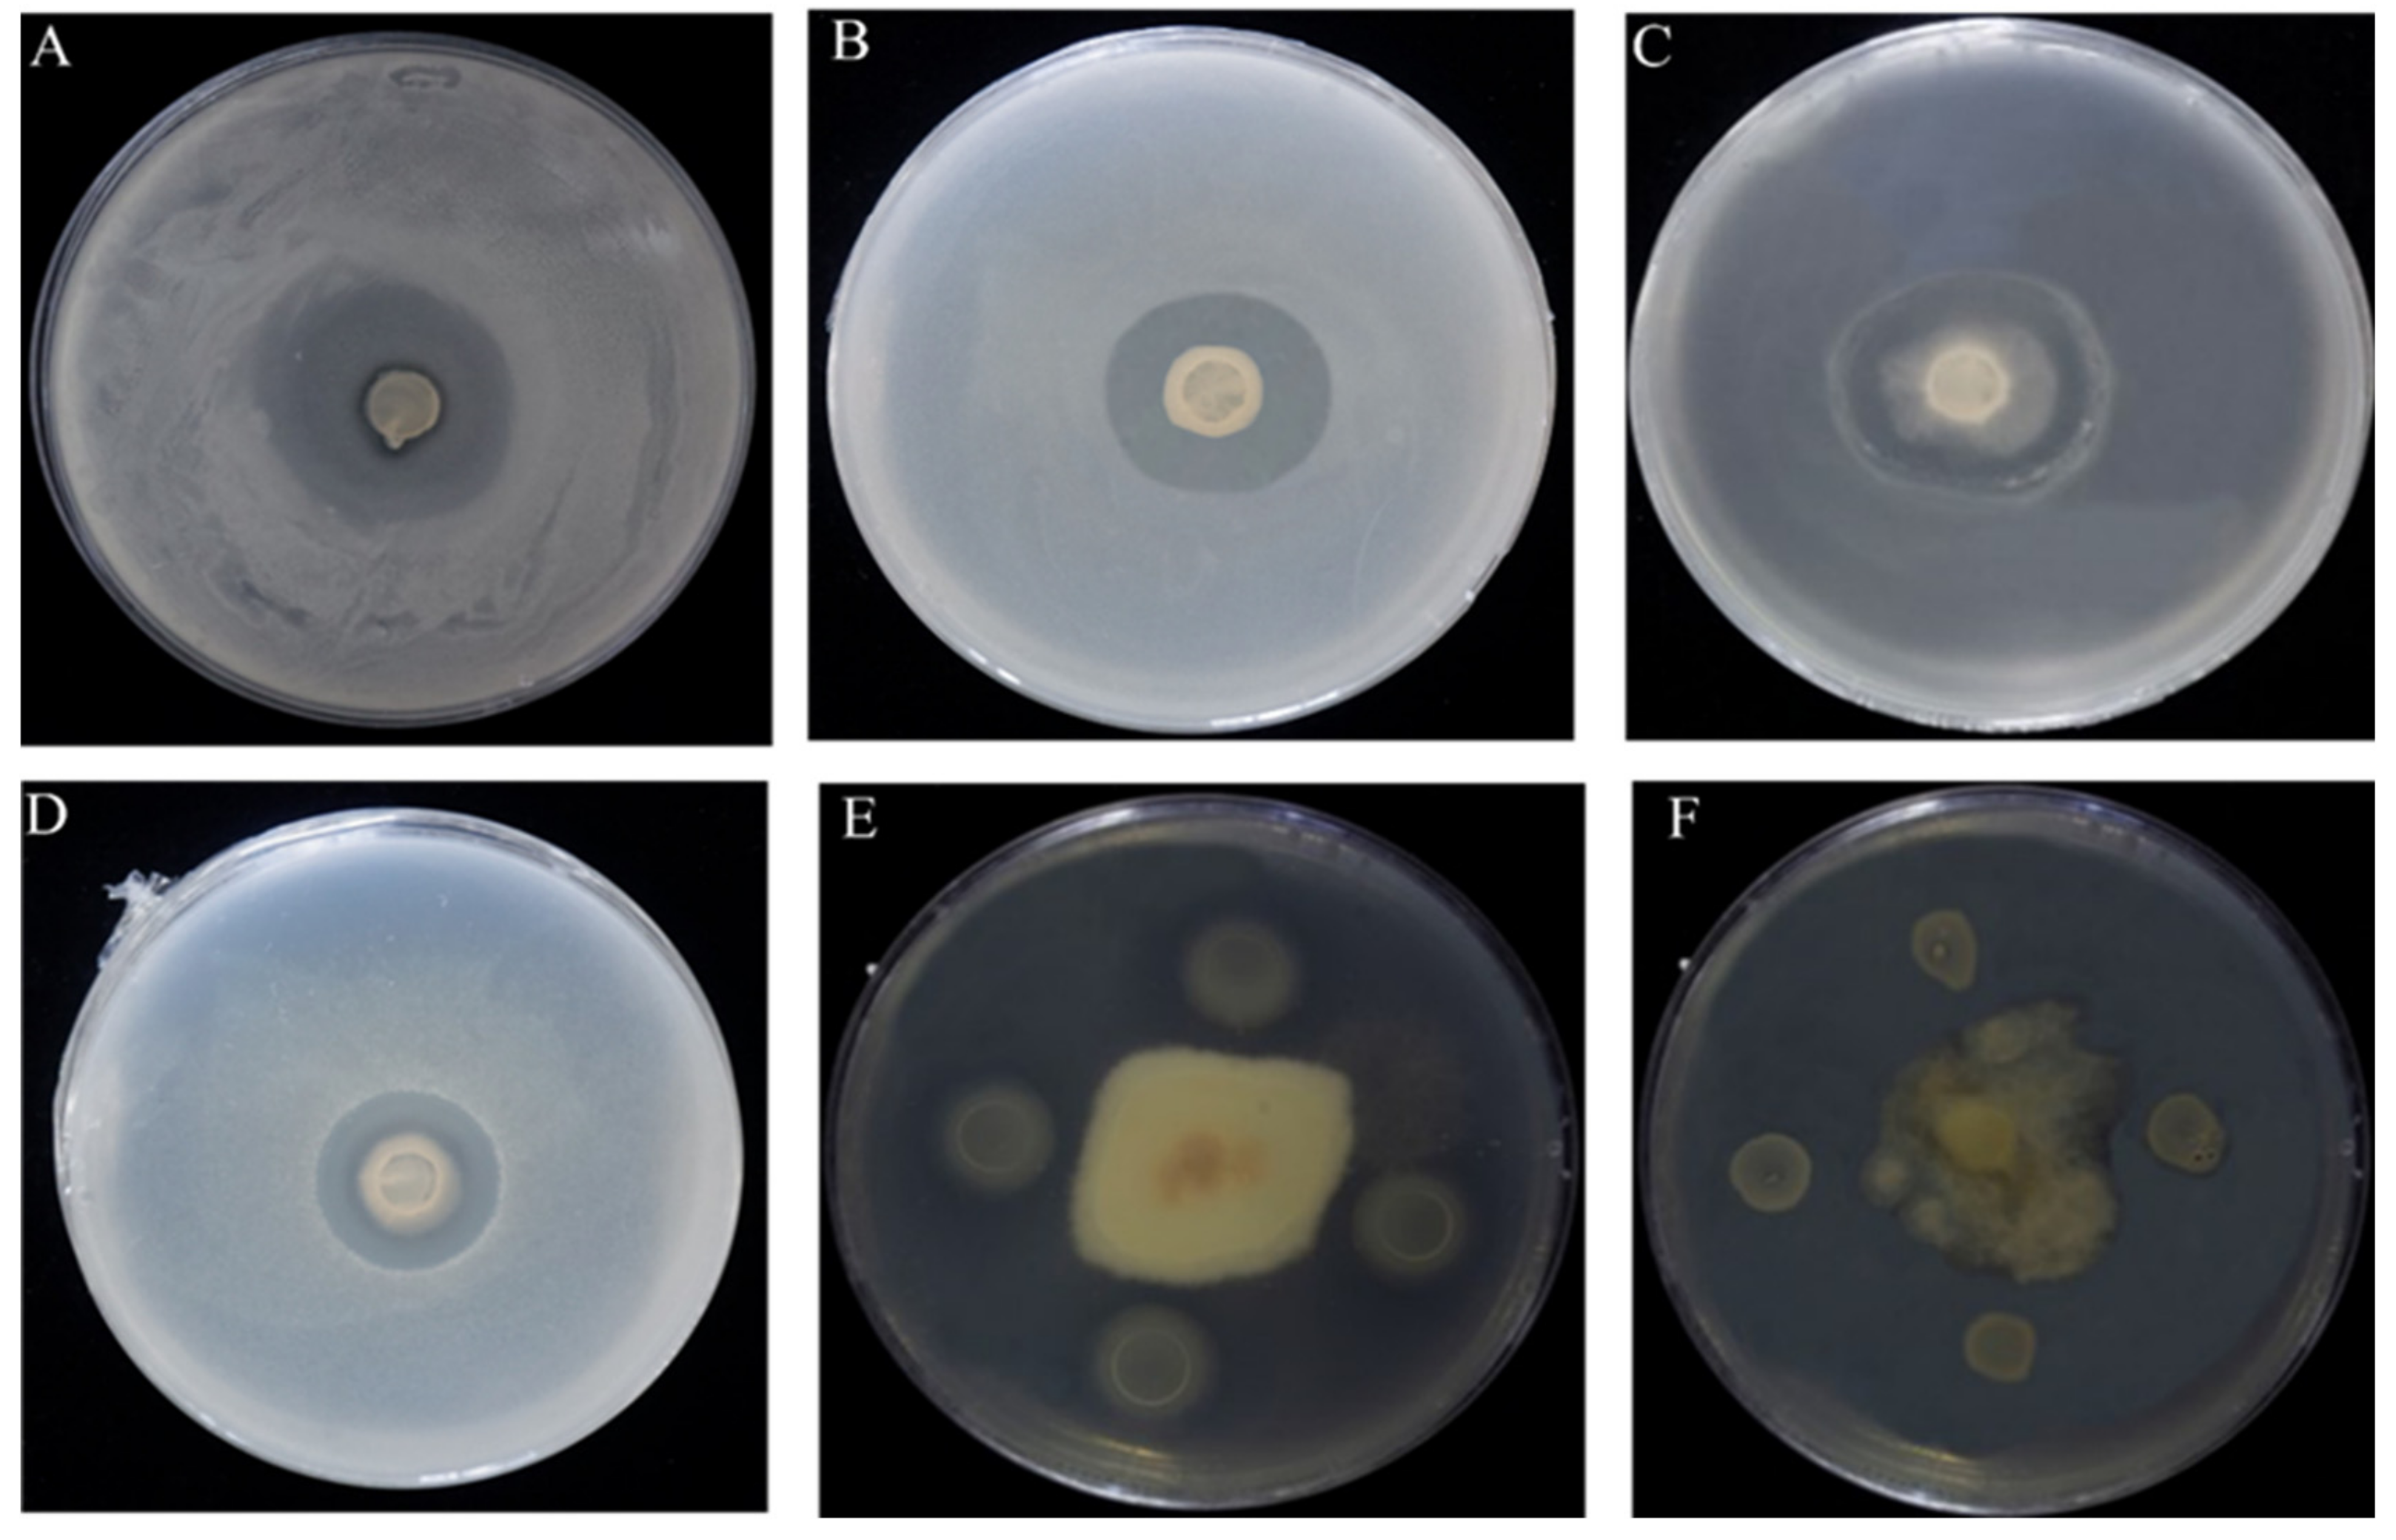
Biology 12 01231 g002
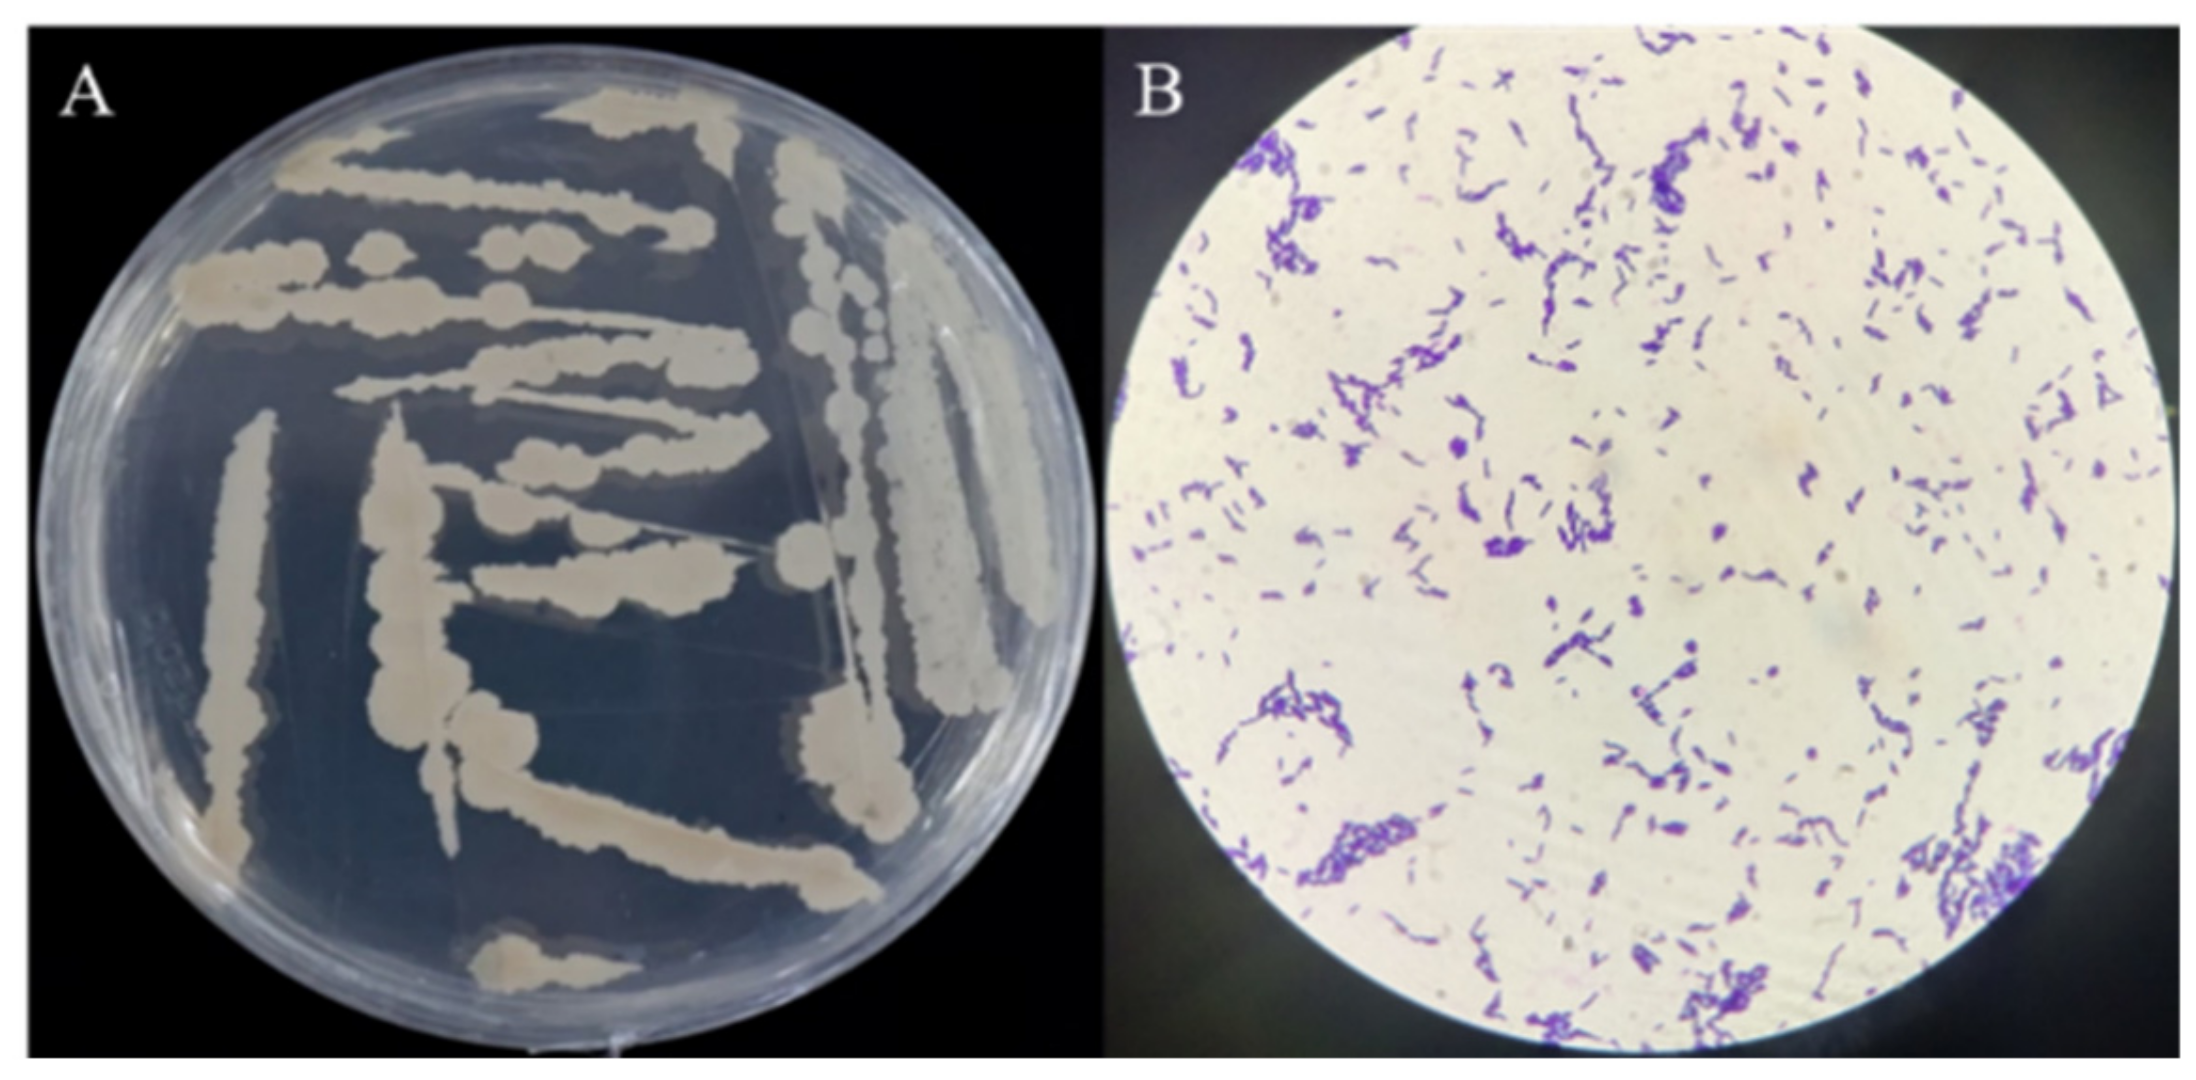
Biology 12 01231 g003

Isolation and Identification of Endophytic Bacteria Bacillus sp. ME9 That Exhibits Biocontrol Activity against Xanthomonas phaseoli pv. manihotis
Abstract
:Simple Summary
Abstract
1. Introduction
2. Materials and Methods
2.1. Isolation and Screening of Antagonistic Bacteria
2.2. Antagonistic Activity Assay against CBB
2.3. Morphology and Molecular Identification of Bacterial Isolates
2.4. Physiological and Biochemical Characterizations of Strain B. subtilis ME9
2.5. In Vivo Evaluation of the Effect of ME9 Isolates on the Development of CBB Disease
2.6. Effects of ME9 Inoculation on Endophytic Bacterial Community in Cassava Leaves
2.7. Statistical Analysis
3. Results
3.1. Isolation of Bacterial Endophytes from Cassava Leaves and Screening of Bacteria with Antagonistic Ability
3.2. Morphological and Molecular Identification of the Optimal Antagonistic Strain ME9
3.3. Analysis of ME9 de Novo Genome Sequencing
3.4. Endophytic Bacteria Strain ME9 Controlled Bacterial Wilt Disease
3.5. Analysis of Changes in Structure of Cassava Endophytic Bacterial Community after Spraying ME9
3.6. Analysis of Changes in Diversity of Cassava Endophytic Bacterial Community after Spraying ME9
3.7. Bacterial Groups with Significant Differences after Spraying ME9
4. Discussion
4.1. Endophytic Microorganisms, an Essential Part of the Plant Microbiome
4.2. Metabolic Characteristics of Endophytic Microorganisms Are Key in the Development of Cassava
4.3. The biocontrol Capacity of B. Subtilis Could Be Associated with Its Ability to Produce Lipopeptides
5. Conclusions
Supplementary Materials
Author Contributions
Funding
Institutional Review Board Statement
Informed Consent Statement
Data Availability Statement
Acknowledgments
Conflicts of Interest
References
- De Souza, A.P.; Massenburg, L.N.; Jaiswal, D.; Cheng, S.; Shekar, R.; Long, S.P. Rooting for cassava: Insights into photosynthesis and associated physiology as aroute to improve yield potential. New Phytol. 2017, 213, 50–65. [Google Scholar] [CrossRef]
- Saithong, T.; Rongsirikul, O.; Kalapanulak, S.; Chiewchankaset, P.; Siriwat, W.; Netrphan, S.; Suksangpanomrung, M.; Meechai, A.; Cheevadhanarak, S. Starch biosynthesis in cassava: A genome-based pathway reconstruction and its exploitation in data integration. BMC Syst. Biol. 2013, 10, 7–75. [Google Scholar] [CrossRef] [PubMed]
- Wang, W.; Feng, B.; Xiao, J.; Xia, Z.; Zhou, X.; Li, P.; Zhang, W.; Wang, Y.; Moller, B.L.; Zhang, P.; et al. Cassava genome from a wild ancestor to cultivated varieties. Nat. Commun. 2014, 5, 5110. [Google Scholar] [CrossRef]
- Latif, S.; Müller, J. Potential of cassava leaves in human nutrition: A review. Trends Food Sci. Tech. 2015, 44, 147–158. [Google Scholar] [CrossRef]
- Ferreira, S.C.; Nakasone, A.K.; Nascimento, S.M.C.; Oliveiram, D.A.; Siqueira, A.S.; Cunha, E.F.M.; Castro, G.L.S.; Souza, C.R.B. Isolation and characterization of cassava root endophytic bacteria with the ability to promote plant growth and control the in vitro and in vivo growth of Phytopythium sp. Physiol. Mol. Plant Pathol. 2021, 116, 101709. [Google Scholar] [CrossRef]
- Parkes, E.Y.; Fregene, M.; Dixon, A.; Boakye-Peprah, B.; Labuschange, M.T. Combining ability of cassava genotypes for cassava mosaic disease and cassava bacterial blight, yield and its related components in two ecological zones in Ghana. Euphytica 2013, 194, 13–24. [Google Scholar] [CrossRef]
- Constantin, E.C.; Cleenwerck, I.; Maes, M.; Baeyen, S.; Van Malderghem, C.; De Vos, P.; Cottyn, B. Genetic characterization of strains named as Xanthomonas axonopodis pv. dieffenbachiae leads to a taxonomic revision of the X. axonopodis species complex. Plant Pathol. 2016, 65, 792–806. [Google Scholar] [CrossRef]
- López, C.E.; Bernal, A.J. Cassava bacterial blight: Using genomics for the elucidation and management of an old problem. Trop. Plant Biol. 2012, 5, 117–126. [Google Scholar] [CrossRef]
- Wonni, I.; Ouedraogo, L.; Dao, S.; Tekete, C.; Koita, O.; Taghouti, G.M.; Verdier, V. First report of cassava bacterial blight caused by Xanthomonas axonopodis pv. Manihotis in Burkina Faso. Plant Dis. 2015, 99, 551. [Google Scholar] [CrossRef]
- Lozano, J.C. Cassava bacterial blight: A manageable disease. Plant Dis. 1986, 70, 1089–1093. [Google Scholar] [CrossRef]
- Wydra, K.; Verdier, V. Occurrence of cassava diseases in relation to environmental, agronomic and plant characteristics. Agric. Ecosyst. Environ. 2002, 93, 211–226. [Google Scholar] [CrossRef]
- Cui, L.X.; Yang, C.D.; Wang, Y.Y.; Ma, T.; Cai, F.F.; Wei, L.J.; Jin, M.J.; Osei, R.; Zhang, J.L.; Tang, M. Potential of an endophytic bacteria Bacillus amyloliquefaciens 3-5 as biocontrol agent against potato scab. Microb. Pathog. 2022, 163, 105382. [Google Scholar] [CrossRef] [PubMed]
- Maksimov, I.V.; Maksimova, T.I.; Sarvarova, E.R.; Blagova, D.K.; Popov, V.O. Endophytic bacteria as effective agents of new-generation biopesticides (Review). Appl. Biochem. Microbiol. 2018, 54, 128–140. [Google Scholar] [CrossRef]
- Afzal, I.; Shinwari, Z.K.; Sikandar, S.; Shahzad, S. Plant beneficial endophytic bacteria: Mechanisms, diversity, host range and genetic determinants. Microbiol. Res. 2019, 221, 36–49. [Google Scholar] [CrossRef]
- Berg, G. Plant-microbe interactions promoting plant growth and health: Perspectives for controlled use of microorganisms in agriculture. Appl. Microbiol. Biotechnol. 2009, 84, 11–18. [Google Scholar] [CrossRef]
- Truyens, S.; Weyens, N.; Cuypers, A.; Vangronsveld, J. Bacterial seed endophytes: Genera, vertical transmission and interaction with plants. Environ. Microbiol. Rep. 2015, 7, 40–50. [Google Scholar] [CrossRef]
- Bacon, C.W.; White, J.F. Functions, mechanisms and regulation of endophytic and epiphytic microbial communities of plants. Symbiosis 2016, 68, 87–98. [Google Scholar] [CrossRef]
- Khalaf, E.M.; Raizada, M.N. Taxonomic and functional diversity of cultured seed associated microbes of the cucurbit family. BMC Microbiol. 2016, 16, 131. [Google Scholar] [CrossRef]
- Zhou, X.R.; Dai, L.; Xu, G.F.; Wang, H.S. A strain of Phoma species improves drought tolerance of Pinus tabulaeformis. Sci. Rep. 2021, 11, 7637. [Google Scholar] [CrossRef]
- Santoyo, G.; Moreno-Hagelsieb, G.; Orozco-Mosqueda, M.C.; Glick, B.R. Plant growth-promoting bacterial endophytes. Microbiol. Res. 2016, 183, 92–99. [Google Scholar] [CrossRef] [PubMed]
- Zhang, Y.; Yu, X.; Zhang, W.; Lang, D.; Zhang, X.; Cui, G.; Zhang, X. Interactions between endophytes and plants: Beneficial effect of endophytes to ameliorate biotic and abiotic stresses in plants. J. Plant Biol. 2019, 62, 1–13. [Google Scholar] [CrossRef]
- Li, J.H.; Wang, E.T.; Feng, W.; Chen, W.X. Genetic diversity and potential for promotion of plant growth detected in nodule endophytic bacteria of soybean grown in Heilongjiang province of China. Soil Biol. Biochem. 2008, 40, 238–246. [Google Scholar] [CrossRef]
- Mageshwaran, V.; Gupta, R.; Singh, S.; Sahu, P.K.; Singh, U.B.; Chakdar, H.; Bagul, S.Y.; Paul, S.; Singh, H.V. Endophytic Bacillus subtilis antagonize soil-borne fungal pathogens and suppress wilt complex disease in chickpea plants (Cicer arietinum L.). Front. Microbiol. 2022, 13, 994847. [Google Scholar] [CrossRef] [PubMed]
- Beris, D.; Theologidis, I.; Skandalis, N.; Vassilakos, N. Bacillus amyloliquefaciens strain MBI600 induces salicylic acid dependent resistance in tomato plants against Tomato spotted wilt virus and Potato virus Y. Sci. Rep. 2018, 8, 10320. [Google Scholar] [CrossRef]
- Chung, S.; Kong, H.; Buyer, J.S.; Lakshman, D.K.; Lydon, J.; Kim, S.D.; Roberts, D.P. Isolation and partial characterization of Bacillus subtilis ME488 for suppression of soilborne pathogens of cucumber and pepper. Appl. Microbiol. Biotechnol. 2008, 80, 115–123. [Google Scholar] [CrossRef]
- Gajbhiye, A.; Alok, R.R.; Meshram, S.U.; Dongre, A.B. Isolation, evaluation and characterization of Bacillus subtilis from cotton rhizospheric soil with biocontrol activity against Fusarium oxysporum. World J. Microbiol. Biotechnol. 2010, 26, 1187–1194. [Google Scholar] [CrossRef]
- Kashyap, A.S.; Manzar, N.; Rajawat, M.V.S.; Kesharwani, A.K.; Singh, R.P.; Dubey, S.C.; Pattanayak, D.; Dhar, S.; Lal, S.K.; Singh, D. Screening and Biocontrol Potential of Rhizobacteria Native to Gangetic Plains and Hilly Regions to Induce Systemic Resistance and Promote Plant Growth in Chilli against Bacterial Wilt Disease. Plants 2021, 10, 2125. [Google Scholar] [CrossRef]
- Thanh, D.T.; Tarn, L.T.T.; Hanh, N.T.; Tuyen, N.H.; Srinivasan, B.; Lee, S.Y.; Park, K.S. Biological Control of Soilborne Diseases on Tomato, Potato and Black Pepper by Selected PGPR in the Greenhouse and Field in Vietnam. Plant Pathol. J. 2009, 25, 263–269. [Google Scholar] [CrossRef]
- Nelson, E.B. Microbial dynamics and interactions in the spermosphere. Annu. Rev. Phytopathol. 2004, 42, 271–309. [Google Scholar] [CrossRef]
- Khan, M.A.; Asaf, S.; Khan, A.L.; Ullah, I.; Ali, S.; Kang, S.M.; Lee, I.J. Alleviation of salt stress response in soybean plants with the endophytic bacterial isolate Curtobacterium sp. SAK1. Ann. Microbiol. 2019, 69, 797–808. [Google Scholar] [CrossRef]
- Eke, P.; Kumar, A.; Sahu, K.P.; Wakam, L.N.; Sheoran, N.; Ashajyothi, M.; Patel, A.; Fekam, F.B. Endophytic bacteria of desert cactus (Euphorbia trigonas Mill) confer drought tolerance and induce growth promotion in tomato (Solanum lycopersicum L.). Microbiol. Res. 2019, 228, 126302. [Google Scholar] [CrossRef]
- Prakash, J.; Arora, N.K. Phosphate-solubilizing Bacillus sp. enhances growth, phosphorus uptake and oil yield of Menthaarvensis L. 3 Biotech 2019, 9, 126. [Google Scholar] [CrossRef] [PubMed]
- Coombs, J.T.; Franco, C.M. Isolation and identification of Actinobacteria from surface-sterilized wheat roots. Appl. Environ. Microbiol. 2003, 69, 5603–5608. [Google Scholar] [CrossRef] [PubMed]
- Ramnani, P.; Gupta, R. Optimization of medium composition for keratinase production on feather by Bacillus licheniformis RG1 using statistical methods involving response surface methodology. Biotechnol. Appl. Biochem. 2004, 40, 191–196. [Google Scholar] [CrossRef]
- Volksh, B.; Ullrich, M.; Fritsche, W. Occurrence of antimicrobial activities of bacteria from soybean leaf spots. J. Basic Microbiol. 1993, 33, 349–355. [Google Scholar] [CrossRef]
- Barra-Bucarei, L.; Iglesias, A.F.; González, M.G.; Aguayo, G.S.; Carrasco-Fernández, J.; Castro, J.F.; Campos, J.O. Antifungal Activity of Beauveria bassiana Endophyte against Botrytis cinerea in Two Solanaceae Crops. Microorganisms 2019, 8, 65. [Google Scholar] [CrossRef]
- Jin, M.J.; Li, S.S.; Tian, W.B.; Yang, C.D.; Wang, Y.Q. Screening, identification and detection of growth-promoting antagonistic endophytic bacteria from Carex moorcroftii in alpine grassland. J. Plant Protect. 2019, 46, 779–786. [Google Scholar] [CrossRef]
- Ben-Zhong, F.U.; Chen, Q.Q.; Wei, M.; Zhu, J.Q.; Yang, X.H.; Guo-Yuan, L.; Zou, L.P.; Wang, D.B. Investigation of walnut bacterial blight pathogens based on 16S-rDNA sequences and RFLP. J. Agric. Univ. Heibei 2016, 39, 63–68. [Google Scholar]
- Wang, L.T.; Lee, F.L.; Tai, C.J.; Kasai, H. Comparison of gyrB gene sequences, 16S rRNA gene sequences and DNA-DNA hybridization in the Bacillus subtilis group. Int. J. Syst. Evol. Microbiol. 2007, 57, 1846–1850. [Google Scholar] [CrossRef]
- Kolmogorov, M.; Yuan, J.; Lin, Y.; Pevzner, P.A. Assembly of long, error-prone reads using repeat graphs. Nat. Biotechnol. 2019, 37, 540–546. [Google Scholar] [CrossRef] [PubMed]
- Koren, S.; Walenz, B.P.; Berlin, K.; Miller, J.R.; Bergman, N.H.; Phillippy, A.M. Canu: Scalable and accurate long-read assembly via adaptive K-mer weighting and repeat separation. Genome Res. 2017, 27, 722–736. [Google Scholar] [CrossRef] [PubMed]
- Hyatt, D.; Chen, G.L.; Locascio, P.F.; Land, M.L.; Larimer, F.W.; Hauser, L.J. Prodigal: Prokaryotic gene recognition and translation initiation site identification. BMC Bioinform. 2010, 11, 119. [Google Scholar] [CrossRef] [PubMed]
- Lagesen, K.; Hallin, P.; Rødland, E.A.; Staerfeldt, H.H.; Rognes, T.; Ussery, D.W. RNAmmer: Consistent and rapid annotation of ribosomal RNA genes. Nucleic Acids Res. 2007, 35, 3100–3108. [Google Scholar] [CrossRef] [PubMed]
- Griffiths-Jones, S.; Bateman, A.; Marshall, M.; Khanna, A.; Eddy, S.R. Rfam: An RNA family database. Nucleic Acids Res. 2003, 31, 439–441. [Google Scholar] [CrossRef]
- Tarailo-Graovac, M.; Chen, N.S. Using RepeatMasker to identify repetitive elements in genomic sequences. Curr. Protoc. Bioinform. 2009, 4, 10–14. [Google Scholar] [CrossRef]
- Edgar, R.C. PILER-CR: Fast and accurate identification of CRISPR repeats. BMC Bioinform. 2007, 8, 18. [Google Scholar] [CrossRef]
- Bland, C.; Ramsey, T.L.; Sabree, F.; Lowe, M.; Brown, K.; Kyrpides, N.C.; Hugenholtz, P. CRISPR recognition tool (CRT): A tool for automatic detection of clustered regularly interspaced palindromic repeats. BMC Bioinform. 2007, 8, 209. [Google Scholar] [CrossRef]
- Akhter, S.; Aziz, R.K.; Edwards, R.A. PhiSpy: A novel algorithm for finding prophages in bacterial genomes that combines similarity-and composition-based strategies. Nucleic Acids Res. 2012, 40, e126. [Google Scholar] [CrossRef]
- Buchfink, B.; Xie, C.; Huson, D.H. Fast and sensitive protein alignment using DIAMOND. Nat. Methods 2015, 12, 59–60. [Google Scholar] [CrossRef]
- Krzywinski, M.; Schein, J.; Birol, I.; Connors, J.; Gascoyne, R.; Horsman, D.; Jones, S.J.; Marra, M.A. Circos: An information aesthetic for comparative genomics. Genome Res. 2009, 19, 1639–1645. [Google Scholar] [CrossRef]
- Dong, X.; Cao, M. Common Bacterial System Identification Manual; Science Press: Beijing, China, 2001. [Google Scholar]
- Yang, F.H.; Zhang, J.; Zhang, H.Y.; Ji, G.H.; Zeng, L.X.; Li, Y.; Yu, C.; Dilantha Fernando, W.G.; Chen, W. Bacterial Blight Induced Shifts in Endophytic Microbiome of Rice Leaves and the Enrichment of Specific Bacterial Strains with Pathogen Antagonism. Front. Plant Sci. 2020, 11, 963. [Google Scholar] [CrossRef]
- Munir, S.; Li, Y.M.; He, P.B.; He, P.F.; He, P.J.; Cui, W.Y.; Wu, Y.X.; Li, X.Y.; Li, Q.; Zhang, S.X. Defeating Huanglongbing Pathogen Candidatus Liberibacter asiaticus With Indigenous Citrus Endophyte Bacillus subtilis L1-21. Front. Plant Sci. 2021, 12, 789065. [Google Scholar] [CrossRef]
- Kim, J.C.; Choi, G.J.; Park, J.H.; Kim, H.T.; Cho, K.Y. Activity against plant pathogenic fungi of phomalactone isolated from Nigrospora sphaerica. Pest Manag. Sci. 2001, 57, 554–559. [Google Scholar] [CrossRef]
- Rueden, C.; Dietz, C.; Horn, M.; Schindelin, J.; Northan, B.; Berthold, M.; Eliceiri, K. ImageJ Ops [Software]. Available online: http://imagej.net/Ops (accessed on 10 February 2017).
- Edgar, R.C. UPARSE: Highly accurate OTU sequences from microbial amplicon reads. Nat. Methods 2013, 10, 996–998. [Google Scholar] [CrossRef]
- Callahan, B.J.; McMurdie, P.J.; Rosen, M.; Han, A.W.; Johnson, A.; Holmes, S.P. DADA2: High-resolution sample inference from Illumina amplicon data. Nat. Methods 2016, 13, 581–583. [Google Scholar] [CrossRef]
- Callahan, M.K.; Yang, A.; Tandon, S.; Xu, Y.; Subudhi, S.K.; Roman, R.A.; Heine, A.I.; Pogoriler, E.; Kuk, D.; Panageas, K.; et al. Evaluation of serum IL-17 levels during ipilimumab therapy: Correlation with colitis. J. Clin. Oncol. 2011, 29, 2505. [Google Scholar] [CrossRef]
- Quast, C.; Pruesse, E.; Yilmaz, P.; Gerken, J.; Schweer, T.; Yarza, P.; Peplies, J.; Glöckner, F.O. The SILVA ribosomal RNA gene database project: Improved data processing and web-based tools. Nucleic Acids Res. 2013, 41, D590–D596. [Google Scholar] [CrossRef] [PubMed]
- Bolyen, E.; Rideout, J.R.; Dillon, M.R.; Bokulich, N.A.; Abnet, C.C.; Al-Ghalith, G.A.; Alexander, H.; Alm, E.J.; Arumugam, M.; Asnicar, F.; et al. Reproducible, interactive, scalable and extensible microbiome data science using QIIME 2. Nat. Biotechnol. 2019, 37, 852–857. [Google Scholar] [CrossRef] [PubMed]
- Sneath, P.H.A.; Mair, N.S.; Sharpe, M.E.; Holt, J.G. Bergey’s Manual of Systematic Bacteriology; Williams and Wilkins: Baltimore, MD, USA; London, UK, 1986. [Google Scholar]
- Guo, M.; Liu, D.H.; Chai, T.J. Complete Genome Sequence of Bacillus subtilis BYS2, a Strain with a Broad Inhibitory Spectrum against Pathogenic Bacteria. Microbiology 2021, 10, e0080321. [Google Scholar] [CrossRef]
- Tian, Y.; Ji, S.; Zhang, E.; Chen, Y.Q.; Xu, G.G.; Chen, X.; Fan, J.Q.; Tang, X.X. Complete genome analysis of Bacillus subtilis TY-1 reveals its biocontrol potential against tobacco bacterial wilt. Mar. Genom. 2023, 68, 101018. [Google Scholar] [CrossRef] [PubMed]
- Segata, N.; Izard, J.; Waldron, L.; Gevers, D.; Miropolsky, L.; Garrett, W.S.; Huttenhower, C. Metagenomic biomarker discovery and explanation. Genome Biol. 2011, 12, R60. [Google Scholar] [CrossRef]
- Hardoim, P.R.; van Overbeek, L.S.; Berg, G.; Pirttilä, A.M.; Compant, S.; Campisano, A.; Döring, M.; Sessitsch, A. The hidden world within plants: Ecological and evolutionary considerations for defining functioning of microbial endophytes. Microbiol. Mol. Biol. Rev. 2015, 79, 293–320. [Google Scholar] [CrossRef]
- Frank, A.; Saldierna Guzmán, J.; Shay, J. Transmission of bacterial endophytes. Microorganisms 2017, 5, 70. [Google Scholar] [CrossRef]
- Hassan, R.; El-Naggar, W.; Abd El-Aziz, A.M.; Shaaban, M.; Kenawy, H.I.; Ali, Y.M. Immunization with outer membrane proteins (OprF and OprI) and flagellinB protects mice from pulmonary infection with mucoid and nonmucoid Pseudomonas aeruginosa. J. Microbiol. Immunol. 2018, 51, 312–320. [Google Scholar] [CrossRef]
- Kumar, M.; Brader, G.; Sessitsch, A.; Mäki, A.; van Elsas, J.D.; Nissinen, R. Plants assemble species specific bacterial communities from common core taxa in three arcto-alpine climate zones. Front. Microbiol. 2017, 8, 12. [Google Scholar] [CrossRef]
- Zheng, L.N.; Zhang, J.P.; Wu, X.; Gu, X.H.; Wang, S.L.; Zhang, H. A novel biocontrol strain Pantoea jilinensis D25 for effective biocontrol of tomato gray mold (causative agent Botrytis cinerea). Biol. Control 2021, 164, 104766. [Google Scholar] [CrossRef]
- Lyngwi, N.; Joshi, S. Economically important Bacillus and related genera: A mini review. In Biology of Useful Plants and Microbes; Narosa Publishing House: Delhi, India, 2014; Volume 3, pp. 33–43. [Google Scholar]
- Kumar, A.; Prakash, A.; Johri, B.N. Bacillus as PGPR in crop ecosystem. In Bacteria in Agrobiology: Crop Ecosystems; Springer: Berlin/Heidelberg, Germany, 2011; pp. 37–59. [Google Scholar]
- Kumar, P.; Dubey, R.C.; Maheshwari, D.K. Bacillus strains isolated from rhizosphere showed plant growth promoting and antagonistic activity against phytopathogens. Microbiol. Res. 2012, 167, 493–499. [Google Scholar] [CrossRef] [PubMed]
- Samedi, L.; Charles, A.L. Isolation and characterization of potential probiotic Lactobacilli from leaves of food plants for possible additives in pellet feeding. Ann. Agric. Sci. 2019, 64, 55–62. [Google Scholar] [CrossRef]
- Bolivar-Anillo, H.J.; González-Rodríguez, V.E.; Cantoral, J.M.; García-Sánchez, D.; Collado, I.G.; Garrido, C. Endophytic Bacteria Bacillus subtilis, Isolated from Zea mays, as Potential Biocontrol Agent against Botrytis cinerea. Biology 2021, 10, 492. [Google Scholar] [CrossRef]
- Hawes, M.; Allen, C.; Turgeon, B.G.; Curlango-Rivera, G.; Minh, T.T.; Huskey, D.A.; Xiong, Z. Root border cells and their role in plant defense. Annu. Rev. Phytopathol. 2016, 54, 143–161. [Google Scholar] [CrossRef] [PubMed]
- Formela, M.; Samardakiewicz, S.; Marczak, Ł.; Nowak, W.; Narożna, D.; Bednarski, W.; Kasprowicz-Maluśki, A.; Morkunas, I. Effects of endogenous signals and Fusarium oxysporum on the mechanism regulating genistein synthesis and accumulation in yellow lupine and their impact on plant cell cytoskeleton. Molecules 2014, 19, 13392–13421. [Google Scholar] [CrossRef]
- Berger, S.; Sinha, A.K.; Roitsch, T. Plant physiology meets phytopathology: Plant primary metabolism and plant-pathogen interaction. J. Exp. Bot. 2007, 58, 4019–4026. [Google Scholar] [CrossRef] [PubMed]
- Denoux, C.; Galletti, R.; Mammarella, N.; Gopalana, S.; Werckb, D.L.; De Lorenzoc, G.; Ferraric, S.; Ausubela, F.M.; Dewdneya, J. Activition of defence response pathways by OGs and flg22 elicitors in Arabidopsis seedings. Mol. Plant 2008, 208, 423–445. [Google Scholar] [CrossRef] [PubMed]
- Kano, A.; Hosotani, K.; Gomi, K. D-Psicose induces upregulation of defense-related-genes and resistance in rice against a bacterial blight. Plant Physiol. 2011, 168, 1852–1857. [Google Scholar] [CrossRef] [PubMed]
- Singh, R.K.; Tiwari, S.P.; Rai, A.K.; Mohapatra, T.M. Cyanobacteria: An emerging source for drug discovery. J. Antibiot. 2011, 42, 401–412. [Google Scholar] [CrossRef]
- Leno, P.; Sheen, J. Sugar and hormone connections. Trends Plant Sci. 2003, 8, 110–111. [Google Scholar] [CrossRef] [PubMed]
- Hayes, M.A.; Feechan, A.; Dry, I.B. Involvement of Abscisic Acid in the Coordinated Regulation of a Stress-Inducible Hexose Transporter (VvHTS) and a Cell wall invertase in grapevine in response to biotrophic fungal infection. Plant Physiol. 2010, 153, 211–221. [Google Scholar] [CrossRef]
- Smeekens, S.; Ma, J.K.; Hanson, J.; Rolland, E. Sugar signals and molecular networks controlling plant growth. Curr. Opin. Plant Biol. 2010, 13, 274. [Google Scholar] [CrossRef]
- Kim, M.; Lee, S.Y.; Park, K.S.; Jeong, E.J.; Ryu, C.M.; Choi, D.; Pai, H.S. Comparative microarray analysis of programmed cell death induced by proteasome malfunction and hypersensitive response in plants. Biochem. Biophys. Res. Commun. 2006, 342, 514–521. [Google Scholar] [CrossRef]
- Yang, B.; Sugio, A.; White, F.F. Os8N3 is a host disease susceptibility gene for bacterial blight of rice. Proc. Natl. Acad. Sci. USA 2006, 103, 10503–10508. [Google Scholar] [CrossRef]
- Lee, S.J.; Trịnh, C.S.; Lee, W.J.; Jeong, C.Y.; Truong, H.A.; Chung, N.Y.; Kang, C.S.; Lee, H. Bacillus subtilis strain L1 promotes nitrate reductase activity in Arabidopsis and elicits enhanced growth performance in Arabidopsis, lettuce, and wheat. J. Plant Res. 2020, 133, 231–244. [Google Scholar] [CrossRef]
- Gomaa, O.M.; Kareem, H.A.E.; Selim, N. Nitrate modulation of Bacillus sp. biofilm components: A proposed model for sustainable bioremediation. Biotechnol. Lett. 2021, 43, 2185–2197. [Google Scholar] [CrossRef]
- Osei, R.; Yang, C.; Cui, L.; Wei, L.; Jin, M.; Wei, X. Antagonistic bioagent mechanisms of controlling potato soft rot. Plant Protect. Sci. 2022, 58, 18–30. [Google Scholar] [CrossRef]
- Ongena, M.; Jacques, P. Bacillus lipopeptides: Versatile weapons for plant disease biocontrol. Trends Microbiol. 2008, 16, 115–125. [Google Scholar] [CrossRef]
- Raaijmakers, J.M.; de Bruijn, I.; Nybroe, O.; Ongena, M. Natural functions of lipopeptides from Bacillus and Pseudomonas: More than surfactants and antibiotics. FEMS Microbiol. Rev. 2010, 34, 1037–1062. [Google Scholar] [CrossRef]
- Shafi, J.; Tian, H.; Ji, M. Bacillus species as versatile weapons for plant pathogens: A review. Biotechnol. Equip. 2017, 31, 446–459. [Google Scholar] [CrossRef]
- Dimopolou, A.; Theologidis, I.; Benaki, D.; Koukounia, M.; Zervakou, A.; Diallinas, G.; Hatzinikolaou, D.G.; Skandalis, N. Direct antibiotic activity of bacillibactin broadens the biocontrol range of Bacillus amyloliquefaciens MBI600. mSphere 2021, 6, e0037621. [Google Scholar] [CrossRef]
- Müller, S.; Strack, S.N.; Hoefler, B.C.; Straight, P.D.; Kearns, D.B.; Kirby, J.R. Bacillaene and sporulation protect Bacillus subtilis from predation by Myxococcus xanthus. Appl. Environ. Microb. 2014, 80, 5603–5610. [Google Scholar] [CrossRef] [PubMed]
- Farace, G.; Fernandez, O.; Jacquens, L.; Coutte, F.; Krier, F.; Jacques, P.; Clément, C.; Barka, E.A.; Jacquard, C.; Dorey, S. Cyclic lipopeptides from Bacillus subtilis activate distinct patterns of defence responses in grapevine. Mol. Plant Pathol. 2015, 16, 177–187. [Google Scholar] [CrossRef]

| Strain Number | Bacteriostatic Zone Width (mm) | Antagonistic Effect |
|---|---|---|
| BA (CK) | 3.86 ± 0.62 | + |
| ME2 | 9.40 ± 1.59 | ++ |
| ME9 | 12.06 ± 2.09 | +++ |
| ME13 | 5.16 ± 1.35 | ++ |
| ME21 | 5.49 ± 0.51 | ++ |
| ME3 | 3.60 ± 0.84 | + |
| ME5 | 5.17 ± 1.74 | ++ |
| ME52 | 3.88 ± 0.32 | + |
| ME59 | 0.58 ± 0.18 | + |
| ME62 | 2.25 ± 0.73 | + |
| ME81 | 1.48 ± 0.90 | + |
| ME85 | 2.26 ± 0.74 | + |
| ME97 | 1.24 ± 0.21 | + |
| ME126 | 2.38 ± 0.77 | + |
| ME139 | 2.33 ± 1.08 | + |
| ME142 | 4.64 ± 0.86 | + |
| ME148 | 1.55 ± 0.35 | + |
| ME152 | 5.2 ± 0.38 | ++ |
| ME154 | 5.13 ± 0.77 | ++ |
| ME159 | 4.52 ± 1.05 | + |
| ME160 | 3.03 ± 1.02 | + |
| ME221 | 6.34 ± 0.31 | ++ |
| ME222 | 2.98 ± 0.47 | + |
| ME233 | 3.80 ± 0.27 | + |
| ME234 | 1.55 ± 0.67 | + |
| ME262 | 3.82 ± 0.31 | + |
| ME267 | 1.83 ± 1.13 | + |
| ME269 | 2.50 ± 0.76 | + |
| ME278 | 3.56 ± 0.52 | + |
| Test Item | Result |
|---|---|
| Gram stain | + |
| Catalase | + |
| Methyl red | + |
| V-P | + |
| Gelatin liquefaction | + |
| Nitrate reductase | + |
| Citrate | – |
| Amylolysis | + |
| Indole reaction | – |
| Salt tolerance | |
| 3% | + |
| 5% | + |
| 7% | + |
| 9% | + |
| 12% | – |
| pH | |
| 3 | + |
| 4 | + |
| 5 | + |
| 6 | + |
| 7 | + |
| 8 | + |
| 9 | + |
| 10 | – |
| 11 | – |
| Strain | Closest Type Strain | Reference Sequence | Taxonomy (Genus) | Identity (%) |
|---|---|---|---|---|
| ME2 | Bacillus velezensis | CP090905.1 | Bacillus | 100.00 |
| ME9 | Bacillus subtilis | CP070485.1 | Bacillus | 100.00 |
| ME13 | Bacillus cereus | AP023005.1 | Bacillus | 100.00 |
| ME21 | Brevibacillus laterosporus | CP032410.1 | Brevibacillus | 99.93 |
| ME3 | Bacillus altitudinis | MN543858.1 | Bacillus | 100.00 |
| ME5 | Bacillus licheniformis | MT368012.1 | Bacillus | 100.00 |
| ME52 | Curtobacterium oceanosedimentum | NR_104839.1 | Curtobacterium | 98.38 |
| ME59 | Leclercia adecarboxylata | KJ184954.1 | Leclercia | 95.18 |
| ME62 | Bacillus subtilis | KM083800.1 | Bacillus | 99.13 |
| ME81 | Pantoea agglomerans | KX233853.1 | Pantoea | 87.54 |
| ME85 | Bacillus sp. | JF783985.1 | Bacillus | 97.31 |
| ME97 | Pantoea agglomerans | KX233853.1 | Pantoea | 87.54 |
| ME126 | Bacillus subtilis | MK824707.1 | Bacillus | 99.34 |
| ME139 | Leclercia adecarboxylata | MF716711.1 | Leclercia | 99.02 |
| ME142 | Leclercia adecarboxylata | MN314177.1 | Leclercia | 81.48 |
| ME148 | Lelliottia amnigena | MH127568.1 | Lelliottia | 97.32 |
| ME152 | Curtobacterium albidum | MN889264.1 | Curtobacterium | 99.35 |
| ME154 | Bacillus subtilis | CP070485.1 | Bacillus | 100.00 |
| ME159 | Bacillus subtilis | KY621524.1 | Bacillus | 98.13 |
| ME160 | Bacillus subtilis | OK314473.1 | Bacillus | 96.92 |
| ME221 | Bacillus subtilis | KF641841.1 | Bacillus | 97.14 |
| ME222 | Pseudomonas fulva | CP014025.1 | Pseudomonas | 100.00 |
| ME233 | Lelliottia amnigena | MH127568.1 | Lelliottia | 97.32 |
| ME234 | Pseudomonas oryzihabitans | MN889339.1 | Pseudomonas | 98.96 |
| ME262 | Bacillus subtilis | AB210968.1 | Bacillus | 99.05 |
| ME267 | Pantoea rodasii | MN036531.1 | Pantoea | 98.97 |
| ME269 | Bacillus subtilis | MN704432.1 | Bacillus | 98.22 |
| ME278 | Bacillus subtilis | OM320445.1 | Bacillus | 97.82 |
| Genomic Features | ME9 | B. subtilis BYS2 | B. subtilis TY-1 |
|---|---|---|---|
| Genome size (bp) | 4,215,379 | 4,030,791 | 4,030,269 |
| Total number of contigs | 1 | 1 | 1 |
| G + C content (%) | 43.51 | 43.88 | 43.88 |
| Protein coding genes | 4225 | 3914 | 3960 |
| rRNAs | 30 | 30 | 30 |
| tRNAs | 85 | 86 | 86 |
| Reference | This study | [62] | [63] |
| Cluster ID | Type | Start | End | Similar Cluster | Similarity (%) | Gene No. |
|---|---|---|---|---|---|---|
| Cluster1 | Sactipeptide-Head_to_tail | 203,539 | 226,492 | Sporulation_killing_factor_skfA_biosynthetic | 100 | 23 |
| Cluster2 | Nrps | 356,566 | 421,957 | Surfactin biosynthetic | 82 | 42 |
| Cluster3 | Cf_putative | 430,220 | 445,726 | - | - | 15 |
| Cluster4 | Cf_putative | 792,277 | 811,041 | - | - | 13 |
| Cluster5 | Cf_putative | 905,411 | 926,022 | - | - | 21 |
| Cluster6 | Cf_fatty_acid | 1,082,363 | 1,103,340 | - | - | 18 |
| Cluster7 | Cf_putative | 1,105,596 | 1,118,226 | - | - | 13 |
| Cluster8 | Cf_putative | 1,122,458 | 1,130,297 | Zwittermycin A biosynthetic | 18 | 7 |
| Cluster9 | Terpene | 1,149,536 | 1,170,339 | - | - | 21 |
| Cluster10 | Cf_fatty_acid | 1,197,815 | 1,218,753 | Citrulline biosynthetic | 18 | 20 |
| Cluster11 | Cf_putative | 1,285,185 | 1,309,397 | - | - | 23 |
| Cluster12 | Nrps-Transatpks-Otherks | 1,768,293 | 1,878,119 | Bacillaene biosynthetic | 100 | 51 |
| Cluster13 | Nrps | 1,934,123 | 2,017,555 | Fengycin biosynthetic | 100 | 41 |
| Cluster14 | Terpene | 2,091,767 | 2,113,665 | - | - | 19 |
| Cluster15 | Glycocin | 2,259,120 | 2,279,290 | Sublancin 168 biosynthetic | 100 | 25 |
| Cluster16 | T3pks | 2,296,555 | 2,337,652 | - | - | 43 |
| Cluster17 | Cf_putative | 2,464,156 | 2,473,581 | - | - | 10 |
| Cluster18 | Cf_putative | 2,780,797 | 2,789,215 | - | - | 9 |
| Cluster19 | Cf_putative | 3,087,983 | 3,097,411 | - | - | 9 |
| Cluster20 | Cf_saccharide | 3,147,556 | 3,177,167 | - | - | 20 |
| Cluster21 | Nrps | 3,260,110 | 3,309,851 | Bacillibactin biosynthetic | 100 | 43 |
| Cluster22 | Cf_putative | 3,443,950 | 3,450,117 | - | - | 7 |
| Cluster23 | Cf_saccharide | 3,508,590 | 3,534,024 | - | - | 25 |
| Cluster24 | Other | 3,583,412 | 3,624,158 | - | - | 37 |
| Cluster25 | Cf_saccharide | 3,639,465 | 3,690,036 | Teichuronic acid biosynthetic | 100 | 40 |
| Cluster26 | Cf_putative | 3,725,216 | 3,738,816 | - | - | 12 |
| Cluster27 | Sactipeptide-Head_to_tail | 3,825,676 | 3,847,287 | Subtilosin A biosynthetic | 100 | 19 |
| Cluster28 | Sactipeptide-Head_to_tail | 3,850,033 | 3,918,547 | Subtilosin A biosynthetic | 100 | 68 |
| Cluster29 | Cf_putative | 3,998,714 | 4,004,500 | Bacillomycin biosynthetic | 40 | 6 |
| Cluster30 | Cf_putative | 4,084,162 | 4,103,024 | - | - | 18 |
Disclaimer/Publisher’s Note: The statements, opinions and data contained in all publications are solely those of the individual author(s) and contributor(s) and not of MDPI and/or the editor(s). MDPI and/or the editor(s) disclaim responsibility for any injury to people or property resulting from any ideas, methods, instructions or products referred to in the content. |
© 2023 by the authors. Licensee MDPI, Basel, Switzerland. This article is an open access article distributed under the terms and conditions of the Creative Commons Attribution (CC BY) license (https://creativecommons.org/licenses/by/4.0/).
Share and Cite
Feng, Y.; Zhang, Y.; Shah, O.U.; Luo, K.; Chen, Y. Isolation and Identification of Endophytic Bacteria Bacillus sp. ME9 That Exhibits Biocontrol Activity against Xanthomonas phaseoli pv. manihotis. Biology 2023, 12, 1231. https://doi.org/10.3390/biology12091231
Feng Y, Zhang Y, Shah OU, Luo K, Chen Y. Isolation and Identification of Endophytic Bacteria Bacillus sp. ME9 That Exhibits Biocontrol Activity against Xanthomonas phaseoli pv. manihotis. Biology. 2023; 12(9):1231. https://doi.org/10.3390/biology12091231
Chicago/Turabian StyleFeng, Yating, Yijie Zhang, Obaid Ullah Shah, Kai Luo, and Yinhua Chen. 2023. "Isolation and Identification of Endophytic Bacteria Bacillus sp. ME9 That Exhibits Biocontrol Activity against Xanthomonas phaseoli pv. manihotis" Biology 12, no. 9: 1231. https://doi.org/10.3390/biology12091231
APA StyleFeng, Y., Zhang, Y., Shah, O. U., Luo, K., & Chen, Y. (2023). Isolation and Identification of Endophytic Bacteria Bacillus sp. ME9 That Exhibits Biocontrol Activity against Xanthomonas phaseoli pv. manihotis. Biology, 12(9), 1231. https://doi.org/10.3390/biology12091231

